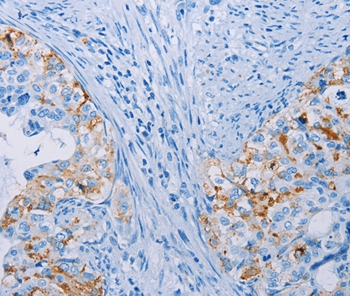
Anti-CA10 Antibody

CA10 Antibody
ORB252022
ApplicationsImmunoHistoChemistry
Product group Antibodies
ReactivityHuman, Mouse
TargetCA10
Overview
- SupplierBiorbyt
- Product NameCA10 Antibody
- Delivery Days Customer16
- ApplicationsImmunoHistoChemistry
- Applications SupplierIHC
- CertificationResearch Use Only
- ClonalityMonoclonal
- ConjugateUnconjugated
- Gene ID56934
- Target nameCA10
- Target descriptioncarbonic anhydrase 10
- Target synonymsCA-RPX, CARPX, HUCEP-15, carbonic anhydrase-related protein 10, CA-RP X, CARP X, carbonic anhydrase X, carbonic anhydrase-related protein X, cerebral protein-15, epididymis secretory sperm binding protein
- HostRabbit
- Protein IDQ9NS85
- Protein NameCarbonic anhydrase-related protein 10
- Scientific DescriptionCA10 Antibody
- ReactivityHuman, Mouse
- Storage Instruction-20°C,2°C to 8°C
- UNSPSC12352203